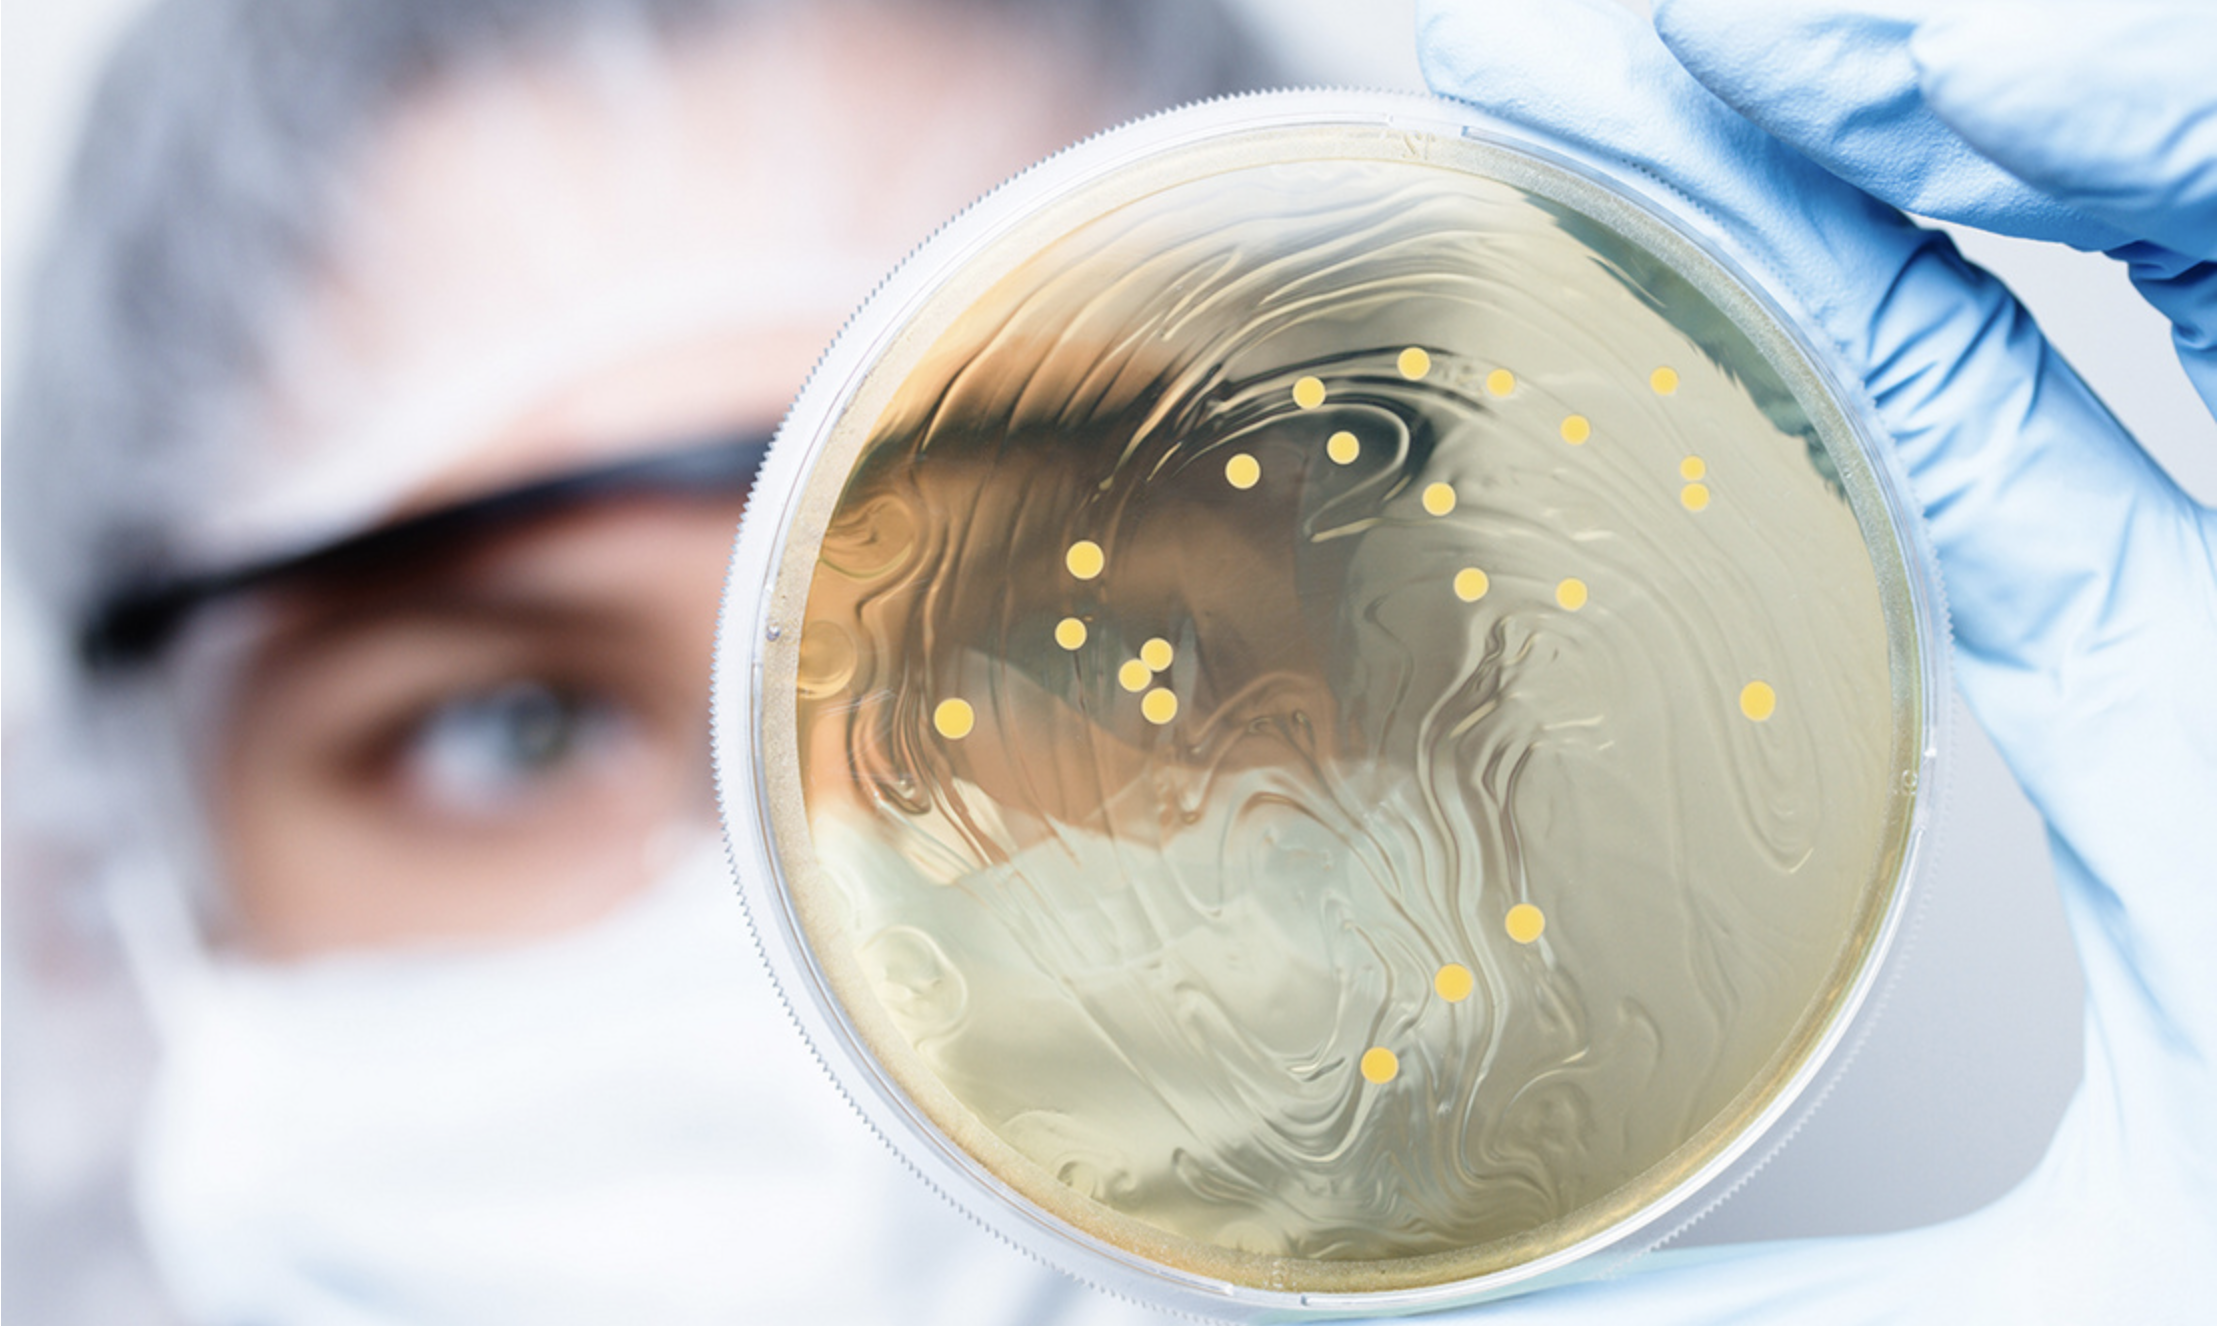
Screenshot 2021 11 22 At 1541 12

2022. június 20.
Akik élőben hallhatták, rajongtak ezért a beszélgetéstért a Millásreggeliben. Téma: ÉTKEZÉSSEL ÉS MOZGÁSSAL A MIGRÉN ELLEN. Ha világosan szeretnél látni a témában, ne hagyd ki! Hallani kell! A Heuréka élmény nem csak a műsorsorozat címe!

2022. június 3.
A Kossuth rádió Felfedező c. műsorában ezúttal két betegünk meséli el gyógyulásuk történetét. Andrea irritábilis bélszindrómától (IBS) szenvedett évekig, Zsuzsának pedig a nem-alkoholos zsímáj betegség okozott kellemetlen tüneteket. Mindkettejük problémájának oka a mikrobiomban volt keresendő, és a megoldást is a célzott kezelés és a mikrobiom helyreállítása jelentette. A stúdióban Dr. Schwab Richárd, belgyógyász, gasztroenterológus és Révész Anett, dietetikus mondja el, a diagnosztika és a sikeres kezelések részleteit.
A 2022 május 31 -ei műsor itt hallható.

2022. május 24.
A Klasszik rádió Otthonról hoztam rovatában, Dr. Tóth Adrián, neurológus beszélgetett Bálint Edinával a Parkinson-kórról 5x10 percben, rendkívül érdekfeszítő és közérthető módon. Mindenkinek érdemes meghallgatni, akit érint a betegség vagy csak érdeklődik.

2022. április 8.
A Klasszik Rádió vendége volt klinikánk neurológusa Dr. Tóth Adrián. Az emésztőrendszer és az agy összefüggéseiről - avagy a bél-agy tengelyről beszélt az Otthonról Hoztam rovatban.

2022. március 31.
alapítójával és tudományos igazgatójával, Dr. Peták Istvánnal beszélgetett Rónai Egon a Húzósban.
Ha kíváncsi vagy arra, hogy hol tart a rákkutatás, hogy van-e esély arra, hogy megtalálják a rák ellenszerét, hogyan lelnek rá a daganatot okozó hibás génre a bioinformatika segítségével, és milyen személyre szabott kezelések érhetők el akár itt és most, akkor ezt a podcastot semmiképpen ne hagyd ki! Informatív, közérthető, reménykeltő interjú!

2022. március 28.
Dr. Schwab Richárd, gasztroenterológus a Klasszik FM sorozatában a bélflóra állapota és az egyes betegségek közötti szoros összefüggésekre világít rá. Ilyenek, az elhízás mögött meghúzódó inzulinrezisztencia, a 2-es típusú diabétesz, a magas vérnyomás, valamint a migrén is. Gondolatébresztő beszélgetések, meghallgatásra érdemesek! A doktor urat Bálint Edina kérdezi.

2022. február 18.
A legfrissebb kutatások szerint a migrén egy gyulladás okozta betegség, és muszáj volna vele foglalkozni, mert az MR kutatások pedig azt támasztják alá, hogy a migrénes rohamok strukturális elváltozásokat okoznak az agyban. Minél többször fáj a feje valakinek, annál valószínűbb, hogy még több rohamra számíthat. A jó hír viszont az, hogy a migrénhez vezető idegrendszeri folyamatokat ma már megértette a tudomány és jó hatásfokkal kezelhető a betegség. Ezen a linken visszahallgatható a Jazzy Randevú című műsora, melyben Dr. Schwab Richárd beszélgetett Bálint Edinával, ezúttal fókuszban: a migrénnel.

2022. január 21.
Az nlc.hu cikkében Dr. Schwab Richárd arról beszél, hogy milyen forradalmi változások történnek a migrén-terápiában, és több orvosi szakterület összedolgozva, hogyan képes megtalálni a rohamokat kiváltó okokat, illetve hatékonyan megelőzni azokat. Mindenkinek, de főként a migréntől rendszeresen szenvedőknek érdemes elolvasni ezt az írást. A MIND Klinika fejfájás centrumában pedig szeretettel várjuk azokat, akiknek a rohamok megkeserítik és gyakran ellehetetlenítik a napjaikat.

2022. január 20.
Az onkológiai betegségek személyre szabott kezeléséről rengeteget hallunk, olvasunk. Nincs olyan hét, hogy ne jöjjenek ki a területen új tudományos eredmények, új gyógyszerek. De elmondhatjuk-e már, hogy a jövő elérkezett? Hozzáférnek a magyar betegek is a személyre szabott ellátáshoz?
2021. november 22.
Van esélye a mai felnőtt generációnak akár 100 évig élni? Milyen szerep jut a mikrobiom állapotának az egészség megőrzésében? Miért fontos az alvás, és mely táplálkozási irányok támogatják szervezetünket legjobban, a legfrissebb tudományos kutatások szerint? Az index.hu Dr. Schwab Richárdot, klinikánk vezető gasztroenterológusát kérdezte. Olvassátok el, informatív és közérthető!

2021. október 22.
2021. október 21-én klinikánk neurológusa Dr. Tóth Adrián és gasztroenterológusa Dr. Schwab Richárd beszélgetett Rangos Katalin mikrofonja előtt a Heti Vizitben. Megtudhatjuk mit keres egy gasztroenterológus és egy neurológus egy ugyanazon rendelésen és hogyan segít a bél-agy tengely menti diagnosztika a migrénesek gondján.

2021. szeptember 29.
Dr. Schwab Richárd és Dr. Peták István a Spirit FM-en arról beszélgettek, hogy az újonnan üzembe helyezett GE csúcstechnológiát képviselő Signa Architect AIR 3T MR készülékkel végezhető funkcionális MR vizsgálatok, milyen óriási változást hozhatnak az onkológiai betegek kezelésében. Ezzel a géppel ugyanis a mesterséges intelligenciának köszönhetően, már 2 hét után vizsgálható a terápiás válasz, míg ma a sztenderd időintervallum világszinten is 6 hét. A gyorsaság pedig minden daganatos megbetegedés esetében kulcsfontosságú faktor. Ez azt is jelenti, hogy a pácienseknek ezentúl nem kell külföldre utazniuk, hogy személyre szabott terápiában részesülhessenek a kezelés során! A riport itt visszahallgatható:

2021. szeptember 9.
Magyarországon 1 200 000 embert érint a migrén és legtöbben saját magukat kezelik és akár naponta szednek be vény nélkül kapható fájdalomcsillapítókat. Ezek a gyógyszerek súlyos vesekárosodást is okozhatnak. Végstádiumú vesebetegek 30-40 %-nál bizonyosodik be, hogy az állapotuk kialakulásában jelentős szerep jutott a fájdalomcsillapítók szedésének. A MIND Klinikánál viszont elérhetőek azok a törzskönyvezett, kifejezetten a migrén kezelésére fejlesztett újgenerációs gyógyszerek, melyek jelentősen csökkentik vagy akár meg is szüntethetik a migrénes rohamokat – többek között erről is beszélt Dr. Mechtler László professzor és Dr. Schwab Richárd (MIND Klinika orvosai és alapítói), a Dr. Jazzy egészségmegőrző rádióműsorban.

2021. szeptember 7.
Klinikánk frissen átadott csúcskategóriás MR készülékéről volt szó az ATV reggeli műsorában. A MIND Klinikán végzett MR vizsgálat gyors és hatékony, mely nagyon fontos szempont a betegeknél. Ugyanakkor forradalmi újdonság, hogy olyan funkcionális vizsgálatok elvégzésére is alkalmas, mellyel akár két hét megállapítható, hogy pl. egy daganatos beteg esetében a választott terápia működik-e. Mivel az MR mellékhatások nélkül végezhető vizsgálat -szemben a más képalkotó eljárásokkal - így a vizsgálat rendszeresen megismételhető, folyamatosan nyomon követve a változásokat, lehetővé téve ezzel a ténylegesen személyre szabott terápiás kezelést.

2021. szeptember 1.
2021. augusztus 31-én Dr. Mechtler László és Dr. Schwab Richárd a Jazzy rádió vendégei voltak. A beszélgetésben rávilágítottak, hogy milyen kapukat nyit meg a korai diagnosztika terén a frissen üzembe helyezett csúcskategóriás MR készülékünk. Ez a gép a nagy felbontásnak és a gyorsaságának köszönhetően képes arra, hogy a sejtek működéséről adjon információt, mindezt nem biztonságosan és ismételhető módon. Ez óriási áttörést jelent például az onkológia területén, hiszen a terápia megkezdését követően, akár már két héten belül, megítélhető a terápiás válasz, azaz, hogy hogyan reagál a beteg a kezelésre, és ez milyen irányt szab a további terápiának. De a neurológiai betegségek korai felismerésében is élenjár ez a technológia. Az interjút érdemes meghallgatni az elejétől a végéig, rengeteg hasznos és érdekes tudnivaló hangzik el!

2021. augusztus 27.
Az Innotéka nyári számában, Dr. Schwab Richárddal, klinikánk vezetőjével és gasztroenterológusával olvasható egy nagyinterjú, pályája meghatározó szereplőiről, sorsfordító momentumairól és fő kutatási területéről, a mikrobiomról.

2021. augusztus 9.
2021. január 22-én a Morning show vendége volt Dr. Schwab Richárd gasztroenterológus, belgyógyász

2021. július 1.
A Manna FM reggeli műsorában Dr. Jarcsnyi Tamás kollégánk volt a vendég. A nyári forróság kapcsán a téma nem volt más mint a fejfájás és hőség kapcsolata.

2021. június 9.
Ezúttal az RTL Édesítő c. műsora látogatott el klinikánkra. Dr. Schwab Richárdot arról kérdezték, hogy hogyan befolyásolja a mikrobiom összetétele a viselkedésünket és az egészségi állapotunkat. A 21. századi ember táplálkozásából javarészt hiányoznak a nyers rostok, nagyon eltértünk az ideálisnak tekinthető testmozgás mennyiségétől, és rengetegen küzdenek alvászavarokkal, melyek mind-mind felboríthatják a bélflóra egyensúlyát. A mikrobiom vizsgálatáról és a kialakult betegségek kezeléséről is szó esik a riportban, mely itt visszanézhető.
